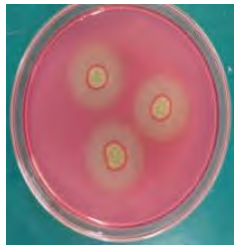

紫外-常压室温等离子体复合诱变高产纤维素酶真菌
来源: 作者: 发布时间:2019-07-26 08:47 浏览量:159
本期为您推荐四川轻化工大学生物工程学院,江南大学生物工程学院邹伟,吴静研究团队发表在《食品与发酵工业》上的一篇文章:紫外-常压室温等离子体复合诱变高产纤维素酶真菌。
文章摘要内容如下:
纤维素是目前世界上含量最丰富的天然可再生资源,纤维素资源的高效开发利用是当前研究热点。纤维素酶由多种复合酶系组成,广泛存在于微生物、原生动物和植物中。但由于纤维素酶产量低、成本高等问题导致纤维素酶的工业应用受到限制,因此高酶活菌株的选育仍然是重要的研究方向。虽然目前发现具有纤维素降解功能的微生物菌属很多,但自然筛选获得的菌株产酶能力有限,通过诱变提高产酶能力仍是常用的方法。
本研究以实验室前期菌株枝孢菌(Cladosporium)B03为出发菌株,经过紫外诱变和常压室温等离子体(atmospheric and room temperature plasma,ARTP)诱变处理,通过刚果红染色初筛和酶活复筛,最终得到产酶能力提高的突变菌株AY-42。其CMC酶活为(582.14±2.32)U/mL,FPA酶活为(92.27±0.23)U/mL,较原始菌株相比CMC酶活提高36.14%,FPA酶活提高97.03%,并且产酶能力能稳定遗传。
ARTP 诱变技术是近年来发展的一种新的诱变技术,在高纯度的氦气作为出发气体下,大量的非平衡性等离子体流作用于微生物的遗传物质,破坏单核苷酸的磷酸二酯键,诱发细胞SOS修复机制从而导致遗传物质突变。ARTP诱变方法具有突变率高、遗传稳定的优点,相对其他操作还具有操作简单、安全的优点,因此受到越来越多的关注和应用。本研究通过紫外-ARTP诱变技术提高枝孢菌B03的产酶能力,为菌株B03应用于纤维素酶生产奠定基础。
文章精彩内容如下:
图3 菌株AY-42刚果红染色

表3 菌株UV-03的ARTP诱变结果

图4 突变菌株AY-42产纤维素酶的遗传稳定性
